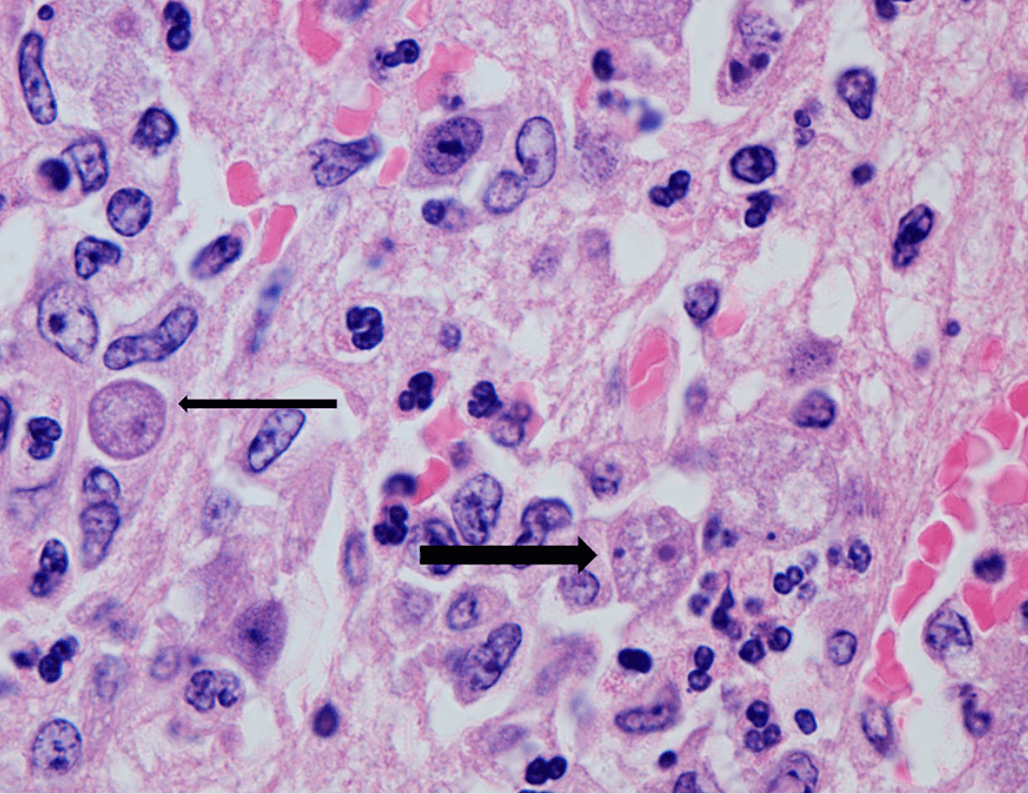
Brain tissue stained with hematoxylin and eosin showing Balamuthia mandrillaris cysts in the neuropil with a thick outer wall and dense internal staining

The Plaque Before the Storm
Clinical Vignette
A 32-year-old man from Peru who immigrated to the United States 2 years ago presents to the emergency department after a witnessed generalized tonic-clonic seizure. His partner reports that he has had worsening daily headaches over the past 5 weeks, along with progressive memory difficulties and uncharacteristic irritability. Over the past 3 days he had become increasingly confused and difficult to rouse.
Approximately 3 months before this presentation, he developed a mildly indurated, erythematous plaque over the bridge of his nose and left cheek. It was initially painless and non-pruritic and he attributed it to sun exposure. He tried over-the-counter hydrocortisone cream without improvement. A dermatology visit 6 weeks later led to a diagnosis of rosacea; he was prescribed topical metronidazole gel and a low-potency topical corticosteroid. The facial plaque did not resolve and appeared to enlarge slightly over the following weeks. He is otherwise healthy with no prior medical history, takes no medications, and does not use alcohol, tobacco, or drugs. He works in landscaping.
On examination he is febrile to 38.4°C, blood pressure 128/78 mmHg, heart rate 102 bpm, and oxygen saturation 98% on room air. He is oriented to person only and has marked psychomotor slowing. There is no nuchal rigidity or photophobia. Cranial nerves are intact. An erythematous, indurated, non-ulcerated plaque measuring approximately 4 × 3 cm is present over the nasal bridge and left medial cheek. The remainder of the examination is unremarkable.
HIV-1/2 antigen-antibody combination test is negative. Basic metabolic panel and complete blood count are within normal limits. MRI of the brain with gadolinium shows multiple T2-hyperintense lesions with ring enhancement in the right parietal and left temporal lobes with mild surrounding edema and no midline shift. Lumbar puncture reveals an opening pressure of 28 cm H₂O, WBC 118 cells/μL (86% lymphocytes, 14% monocytes), protein 104 mg/dL, and glucose 50 mg/dL with a serum glucose of 102 mg/dL. CSF HSV-1 and HSV-2 PCR are negative. Cryptococcal antigen is negative. Cytology shows no malignant cells. Serum Toxoplasma IgG is pending. Brain biopsy is performed and H&E staining reveals uninucleate trophozoites with prominent central nucleoli distributed throughout the parenchyma with surrounding granulomatous inflammation. Specific immunostaining is pending.
Brain tissue (H&E stain): cyst with thick outer wall embedded in the neuropil. Image courtesy of the Centers for Disease Control and Prevention (CDC).
Question 1
Brain biopsy reveals uninucleate trophozoites with surrounding granulomatous inflammation; specific immunostaining is pending. Which of the following is the most likely diagnosis?
Select one option to submit your answer and view live poll results.
Question 2
Specific immunostaining from the CDC confirms the diagnosis. Which of the following is the most appropriate treatment?
Select one option to submit your answer and view live poll results.
References
Visvesvara GS, Moura H, Schuster FL. Pathogenic and opportunistic free-living amoebae: Acanthamoeba spp., Balamuthia mandrillaris, Naegleria fowleri, and Sappinia diploidea. FEMS Immunology & Medical Microbiology. 2007;50(1):1-26.
Deetz TR, Sawyer MH, Billman G, Schuster FL, Visvesvara GS. Successful treatment of Balamuthia amoebic encephalitis: presentation of 2 cases. Clinical Infectious Diseases. 2003;37(10):1304-1312.
Martínez DY, Seas C, Brávard M, et al. Successful miltefosine treatment of Balamuthia mandrillaris granulomatous amebic encephalitis. Antimicrobial Agents and Chemotherapy. 2010;54(10):4485-4487.
Bravo FG, Seas C. Balamuthia mandrillaris amoebic encephalitis: an emerging parasitic infection. Current Infectious Disease Reports. 2012;14(4):391-396.
Centers for Disease Control and Prevention. Balamuthia mandrillaris: About Balamuthia. National Center for Emerging and Zoonotic Infectious Diseases, Division of Parasitic Diseases and Malaria. Accessed March 23, 2026.